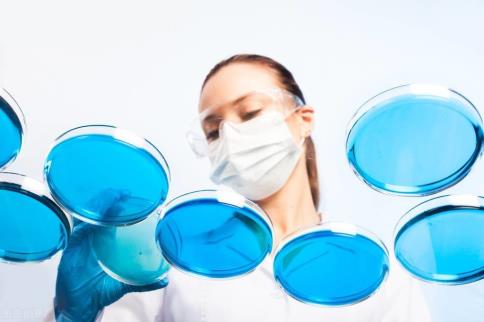
3.jpg

Nature子刊:培養(yǎng)皿里的心肌梗死模型!
南卡羅來(lái)納醫(yī)科大學(xué)和克萊姆森大學(xué)的研究人員報(bào)告說(shuō),他們已經(jīng)開(kāi)發(fā)出用于模擬心肌梗死和藥物心臟毒性的人類心臟器官。

南卡羅來(lái)納醫(yī)科大學(xué)和克萊姆森大學(xué)的研究人員報(bào)告說(shuō),他們已經(jīng)開(kāi)發(fā)出用于模擬心肌梗死和藥物心臟毒性的人類心臟器官。
普通美國(guó)人每40秒就有一次心臟病發(fā)作。然而,研究人員還沒(méi)有一個(gè)模型來(lái)完全描述心臟病發(fā)作后的人類心臟。
來(lái)自南卡羅萊納醫(yī)科大學(xué)(MUSC)和克萊姆森大學(xué)的一個(gè)研究小組最近在《自然生物醫(yī)學(xué)工程》雜志的一篇文章中報(bào)告說(shuō),他們已經(jīng)開(kāi)發(fā)出直徑小于1毫米的人類心臟器官,這與心臟病發(fā)作時(shí)的生理?xiàng)l件非常相似。
該團(tuán)隊(duì)由梅穎領(lǐng)導(dǎo),他是MUSC-克萊姆森生物工程項(xiàng)目的成員,也是生物工程博士。該項(xiàng)目將克萊姆森生物工程師和生物工程博士生安置在MUSC校區(qū),以便他們能夠與臨床醫(yī)生互動(dòng)。這篇文章的主要作者迪倫·理查茲博士是兩所大學(xué)聯(lián)合培養(yǎng)的畢業(yè)生。

理查茲說(shuō):“我們基本上可以將心臟病發(fā)作的復(fù)雜三維特征簡(jiǎn)化為一個(gè)微觀組織模型?!?/p>
這種器官是直徑不到1毫米的三維多細(xì)胞組織,這些器官或微組織的功能與全尺寸的對(duì)應(yīng)器官相似:像人類的心臟一樣跳動(dòng)和收縮。在這個(gè)模型中,多能干細(xì)胞被誘導(dǎo)分裂并成熟為幾種類型的心臟細(xì)胞,然后這些細(xì)胞相互作用并自我組裝形成器官。
傳統(tǒng)上,生物學(xué)家使用培養(yǎng)皿或動(dòng)物模型中的細(xì)胞來(lái)識(shí)別研究中的疾病。這些方法都有各自的缺點(diǎn),器官模型克服了這些缺點(diǎn)。
培養(yǎng)皿中的細(xì)胞在細(xì)胞層面學(xué)習(xí)東西是有好處的,但細(xì)胞在平面上二維生長(zhǎng)是不自然的。
動(dòng)物模型在復(fù)制人體中發(fā)生的事情方面非常有用,但它們只適合于進(jìn)一步的研究。類器官,尤其是心臟類器官,特別適合復(fù)制人類的條件。
理查茲解釋說(shuō),“老鼠的心跳比人類快5到10倍?!?/p>
相反,心臟器官樣組織重建了人的心臟,這與心臟病發(fā)作導(dǎo)致缺氧后的組織功能障礙非常相似。因?yàn)楹茈y在心臟病發(fā)作后立即獲得樣本,我們關(guān)于心臟病發(fā)作的大部分知識(shí)來(lái)自于最初缺氧后很久的觀察。器官樣模型填補(bǔ)了這一空白,使得缺氧后的情況立即可見(jiàn)。
“這有助于我們更好地理解細(xì)胞的短期反應(yīng),進(jìn)而理解瞬時(shí)損傷如何導(dǎo)致長(zhǎng)期損傷,”理查茲說(shuō)。
該模型也使研究人員能夠測(cè)試心臟藥物是否能夠改善心臟病發(fā)作。
理查茲解釋說(shuō):“這有助于我們確定一種藥物是否能有效防止這種損傷或防止缺氧的有害反應(yīng)?!辈y(cè)試在健康心臟中安全的藥物在患病心臟中是否安全。這些信息可以指導(dǎo)醫(yī)生更恰當(dāng)?shù)貫槭装l(fā)心臟病患者開(kāi)藥。
簡(jiǎn)而言之,該模型為研究人員提供了對(duì)心臟病發(fā)作早期事件的理解。梅打算通過(guò)添加免疫細(xì)胞來(lái)使模型更好。免疫細(xì)胞負(fù)責(zé)清除心臟病發(fā)作導(dǎo)致的死亡細(xì)胞。通過(guò)這樣做,他們可以確定免疫細(xì)胞如何在缺氧損傷后的心臟組織重建中發(fā)揮作用。
梅教授還想研究患者的遺傳對(duì)其預(yù)后的影響。這些器官可以幫助我們更全面地了解患者的特定遺傳特征如何影響他們的康復(fù)。
“我們不是第一個(gè)概括細(xì)胞甚至組織水平反應(yīng)的人。然而,我認(rèn)為我們是總結(jié)器官水平反應(yīng)的第一人?!?/p>
這篇文章的共同作者將這項(xiàng)研究獻(xiàn)給他們親愛(ài)的朋友和共同作者克雷格·比森博士,他在他們的文章發(fā)表前死于癌癥。
參考
用于模擬心肌梗塞和藥物心臟毒性的人類心臟器官
(本文為轉(zhuǎn)載)
本文網(wǎng)址:http://www.nbmop.com/news/986.html
相關(guān)標(biāo)簽:醫(yī)學(xué)圖像,醫(yī)學(xué)3D打印,醫(yī)學(xué)3D
最近瀏覽:
相關(guān)產(chǎn)品:
相關(guān)新聞:
- 醫(yī)學(xué)3D寫(xiě)實(shí)模型:提升醫(yī)療診斷與治療
- 從2萬(wàn)元降到600元,河北大學(xué)附屬醫(yī)院3D打印肝臟模型新方式
- 飛利浦醫(yī)學(xué)視覺(jué)分析和量化軟件平臺(tái)集成醫(yī)療模型3D打印功能!
- 騰訊優(yōu)圖開(kāi)源業(yè)界首個(gè)3D醫(yī)療影像大數(shù)據(jù)預(yù)訓(xùn)練模型MedicalNet!
- 醫(yī)學(xué)3D打印技術(shù) 為患者帶來(lái)福音
- 醫(yī)學(xué)3D人體模型,深入解析人體結(jié)構(gòu)與疾病
- 醫(yī)學(xué)3D模型軟件下載,提升醫(yī)學(xué)教育與研究效果
- 昕健醫(yī)療:深耕骨科3D打印技術(shù), 挑戰(zhàn)定制化高端市場(chǎng)昕健醫(yī)療:深耕骨科3D打印技術(shù), 戰(zhàn)斗定制化高端市場(chǎng)
- “私家訂制”、精確醫(yī)療,煙臺(tái)山醫(yī)院將3D打印技巧運(yùn)用于骨科手術(shù)
- 新3D打印服務(wù)可在24小時(shí)內(nèi)交付醫(yī)療模型!


